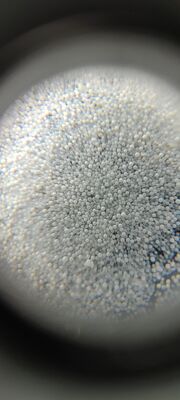
Durable Ceramic Blasting Media Suitable for Removing Surface Contaminants and Preparing Surfaces for Further Processing

Durable Ceramic Blasting Media Suitable for Removing Surface Contaminants and Preparing Surfaces for Further Processing
| Operatingtemperature | Up To 1200°C | Material | Alumina-based Ceramic |
|---|---|---|---|
| Reusability | High, Can Be Reused Multiple Times | Commodity | Ceramic Bead/ball BlastingMedia |
| Bulk Density | ≥2.3 G/cm3 | Process | Melting |
| True Density | 3.86g/cm3 | Applications | Surface Preparation, Cleaning, Deburring, Finishing |
| Highlight | ceramic blasting media for surface cleaning,durable ceramic blasting media,ceramic blasting media for surface preparation |
||
Product Description:
The Ceramic Blasting Media is an advanced abrasive material specially engineered from high-quality alumina-based ceramic. Renowned for its exceptional strength and durability, this media is designed to meet the rigorous demands of various industrial applications, making it an indispensable tool in surface treatment and preparation processes. With a melting point of an impressive 2050°C, the alumina-based ceramic composition ensures that the blasting media maintains its structural integrity even under extreme operating conditions, guaranteeing consistent performance and longevity.
One of the standout features of this ceramic blasting media is its versatility in applications. It is widely utilized in surface preparation, cleaning, deburring, and finishing tasks across numerous industries. Whether the objective is to remove rust, scale, paint, or other contaminants from metal surfaces, or to prepare silicon carbide ceramic parts and other industrial ceramic components for further processing, this blasting media delivers superior results. Its precise abrasive action effectively cleans and smooths surfaces without causing undue wear or damage to the underlying material, making it an ideal choice for delicate industrial ceramic components.
The alumina-based ceramic media is designed for high recyclability, with the capability to be reused between 70 to 90 times depending on the intensity and nature of the blasting operation. This high recyclability not only reduces operational costs but also minimizes material waste, supporting environmentally responsible manufacturing practices. The ability to recycle the blasting media multiple times without significant degradation in performance is a testament to the material’s robustness and the sophisticated manufacturing processes employed in its production.
In comparison to traditional blasting materials, ceramic bead or ball blasting media provides superior hardness and toughness. This makes it particularly effective for treating silicon carbide ceramic parts and other industrial ceramic components where precision and care are paramount. The uniform shape and size of the ceramic beads ensure consistent abrasive action, delivering a smooth and even finish. This consistency is crucial in industries such as aerospace, automotive, and electronics, where the quality of surface finishing directly impacts the performance and longevity of the components.
Moreover, the ceramic blasting media's high melting point of 2050°C means it can withstand high-temperature environments without melting or deforming, unlike some other abrasive materials. This thermal stability allows it to be used in demanding industrial scenarios, including applications involving heat-sensitive materials and processes. The media’s alumina base also provides excellent chemical resistance, enabling it to perform well in various harsh environments without deteriorating.
For companies seeking an efficient, durable, and environmentally friendly blasting media, alumina-based ceramic beads and balls offer an optimal solution. Their ability to effectively clean, deburr, and finish surfaces while protecting sensitive industrial ceramic components and silicon carbide ceramic parts makes them a preferred choice among professionals. Whether used in manufacturing, refurbishment, or maintenance, this ceramic blasting media ensures high-quality results and operational efficiency.
In summary, the alumina-based Ceramic Blasting Media is a premium abrasive solution designed to meet the needs of modern industrial processes. Its high melting point, exceptional durability, and excellent recyclability make it suitable for a wide range of applications including surface preparation, cleaning, deburring, and finishing. Ideal for use on silicon carbide ceramic parts and other industrial ceramic components, this blasting media delivers consistent, high-quality finishes while supporting cost-effective and sustainable operations. As a commodity, ceramic bead or ball blasting media continues to be a critical asset in industries that demand precision, reliability, and performance in their surface treatment processes.
Features:
- Product Name: Ceramic Blasting Media
- Commodity: Ceramic Bead/Ball Blasting Media
- True Density: 3.86 g/cm³
- High reusability – can be reused multiple times
- Operating temperature up to 1200°C
- Melting point of 2050°C
- Effective Ceramic Blasting Abrasive for various industrial applications
- Durable Ceramic Blasting Abrasive ensuring long service life
- Premium quality Ceramic Blasting Media for efficient surface treatment
Technical Parameters:
| Bulk Density | ≥2.3 G/cm³ |
| True Density | 3.86 g/cm³ |
| Operating Temperature | Up To 1200°C |
| Melting Point | 2050°C |
| Recycles | 70-90 |
| Commodity | Ceramic Bead/ball Blasting Media |
| Density | 2.5-3.5 G/cm³ |
| Manufacturing | Melting Method |
| Process | Melting |
| Reusability | High, Can Be Reused Multiple Times |
Applications:
The Fine-tech Ceramic Blasting Media, model number Z210, is an exceptional product designed to meet the rigorous demands of various industrial applications. Certified under ISO9001, this ceramic bead blasting media is perfect for industries requiring high-quality surface preparation, cleaning, deburring, and finishing. With a true density of 3.86g/cm3 and an impressive melting point of 2050°C, the Fine-tech Ceramic Bead Blasting media can operate efficiently at temperatures up to 1200°C, making it suitable for use in harsh and high-temperature environments.
Ceramic Bead Blasting is widely used in the manufacturing and maintenance of industrial ceramic parts, where precision and surface integrity are paramount. The Fine-tech Z210 blasting media ensures gentle yet effective cleaning and finishing of delicate ceramic components without causing damage, thereby prolonging their lifespan and enhancing performance. Its consistent size and hardness guarantee uniform results, making it ideal for industries such as aerospace, automotive, electronics, and medical device manufacturing.
In surface preparation, Fine-tech’s Ceramic Blasting Media excels at removing rust, scale, and old coatings from metal surfaces and industrial ceramic parts, creating a clean and roughened surface that is ideal for subsequent treatments like painting or coating. Additionally, its excellent deburring capabilities help in smoothing out edges and removing burrs from machined parts, ensuring safety and precision in the final product.
Fine-tech offers flexible packaging options including 25kg barrels, 25kg bags, and 1-ton pallets, catering to various scale requirements with a minimum order quantity of 500KG. With a supply ability of 2000 tons per year and delivery times ranging from 5 to 15 workdays, Fine-tech ensures reliable and timely availability of their ceramic bead blasting media. Payment terms such as L/C and T/T provide convenience and security for customers worldwide.
Whether you are working on industrial ceramic parts or need efficient Ceramic Bead Blasting solutions for cleaning, deburring, or finishing, Fine-tech’s Z210 Ceramic Bead Blasting Media is the trusted choice. Its superior physical properties and certified quality make it an indispensable material in modern manufacturing and maintenance processes.